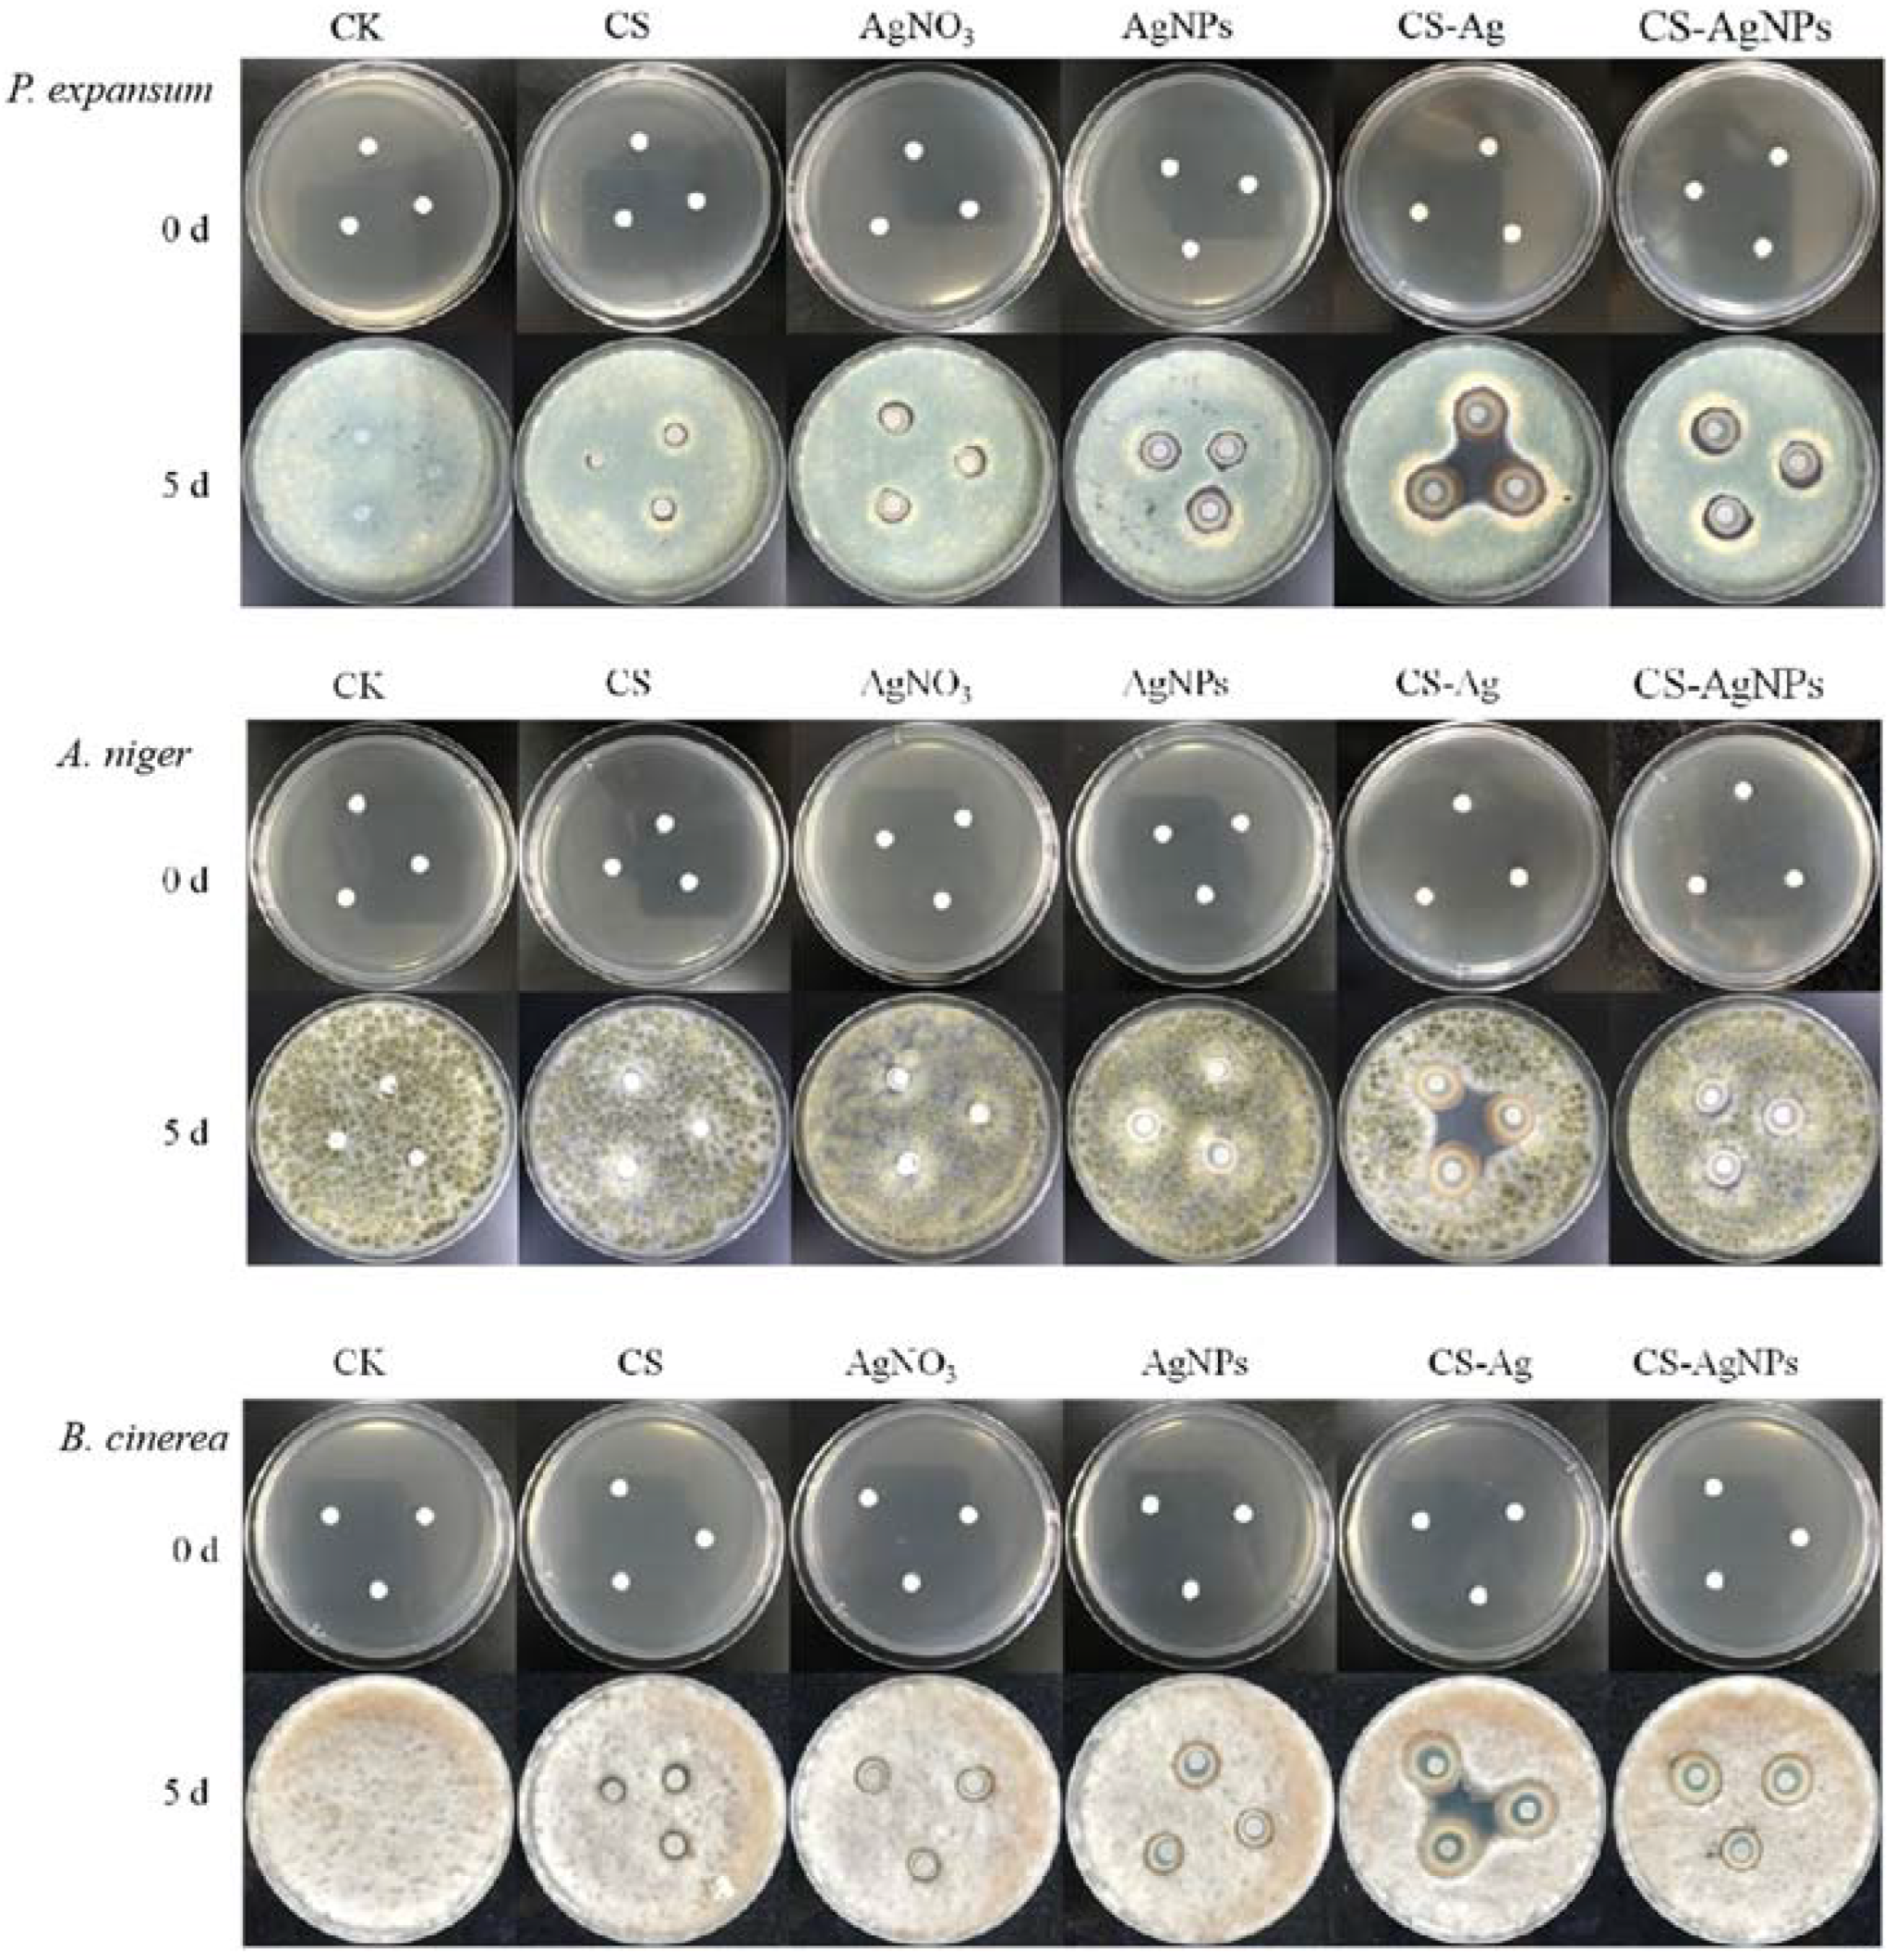

Inhibitory Effect and Mechanism of Chitosan–Ag Complex Hydrogel on Fungal Disease in Grape
Abstract
:1. Introduction
2. Results and Discussion
2.1. Fungal Identification
2.2. CS–Ag Complex Hydrogel Characterization
2.3. Inhibition of CS–Ag Complex Hydrogel on Fungal Disease In Vitro
2.4. Effect of CS–Ag Complex Hydrogel on Grape Disease In Vivo
2.5. Effect of CS–Ag Complex Hydrogel on Fungal Morphology
2.6. Residue of Silver in Grape
3. Materials and Methods
3.1. Fruit Material and Chemical Material
3.2. Fungal Isolation, Identification, Culture, and Spore Suspension
3.3. Characterization
3.4. Preparation of CS–Ag Complex Hydrogel and CS–AgNPs Sol
3.5. Zone of Inhibition Test
3.5.1. Preparation of Fungal Suspension
3.5.2. Antibacterial Experimental Method
3.6. Control of CS–Ag Hydrogel on Fungal Disease In Vivo
3.7. Preservation Test of CS–Ag Hydrogel
3.8. Morphology of Fungal
3.9. Residue of Silver in Grape
4. Conclusions
Supplementary Materials
Author Contributions
Funding
Institutional Review Board Statement
Informed Consent Statement
Data Availability Statement
Acknowledgments
Conflicts of Interest
Sample Availability
References
- Sanzani, S.M.; Reverberi, M.; Geisen, R. Mycotoxins in harvested fruits and vegetables: Insights in producing fungi, biological role, conducive conditions, and tools to manage postharvest contamination. Postharvest Biol. Technol. 2016, 122, 95–105. [Google Scholar] [CrossRef]
- Alkan, N.; Fortes, A.M. Insights into molecular and metabolic events associated with fruit response to post-harvest fungal pathogens. Front. Plant Sci. 2015, 6, 889. [Google Scholar] [CrossRef] [PubMed] [Green Version]
- Chouhan, D.; Mandal, P. Applications of chitosan and chitosan based metallic nanoparticles in agrosciences—A review. Int. J. Biol. Macromol. 2021, 166, 1554–1569. [Google Scholar] [CrossRef] [PubMed]
- Zhang, M.; Wang, G.; Wang, D.; Zheng, Y.; Li, Y.; Meng, W.; Zhang, X.; Du, F.; Lee, S. Ag@MOF-loaded chitosan nanoparticle and polyvinyl alcohol/sodium alginate/chitosan bilayer dressing for wound healing applications. Int. J. Biol. Macromol. 2021, 175, 481–494. [Google Scholar] [CrossRef] [PubMed]
- Zheng, J.; Fan, R.; Wu, H.; Yao, H.; Yan, Y.; Liu, J.; Ran, L.; Sun, Z.; Yi, L.; Dang, L.; et al. Directed self-assembly of herbal small molecules into sustained release hydrogels for treating neural inflammation. Nat. Commun. 2019, 10, 1604. [Google Scholar] [CrossRef]
- Shafique, M.; Sohail, M.; Minhas, M.U.; Khaliq, T.; Kousar, M.; Khan, S.; Hussain, Z.; Mahmood, A.; Abbasi, M.; Aziz, H.C.; et al. Bio-functional hydrogel membranes loaded with chitosan nanoparticles for accelerated wound healing. Int. J. Biol. Macromol. 2021, 170, 207–221. [Google Scholar] [CrossRef]
- Xu, H.; Zhang, L.; Zhang, H.; Luo, J.; Gao, X. Green Fabrication of Chitin/Chitosan Composite Hydrogels and Their Potential Applications. Macromol. Biosci. 2021, 21, 2000389. [Google Scholar] [CrossRef]
- Yang, J.; Shen, M.; Luo, Y.; Wu, T.; Wen, H.; Xie, J. Construction and characterization of Mesona chinensis polysaccharide-chitosan hydrogels, role of chitosan deacetylation degree. Carbohyd. Polym. 2021, 257, 117608. [Google Scholar] [CrossRef]
- Ehtesham Nia, A.; Taghipour, S.; Siahmansour, S. Pre-harvest application of chitosan and postharvest Aloe vera gel coating enhances quality of table grape (Vitis vinifera L. cv. ‘Yaghouti’) during postharvest period. Food Chem. 2021, 347, 129012. [Google Scholar] [CrossRef]
- Mejdoub-Trabelsi, B.; Touihri, S.; Ammar, N.; Riahi, A.; Daami-Remadi, M. Effect of chitosan for the control of potato diseases caused by Fusarium species. J. Phytopathol. 2020, 168, 18–27. [Google Scholar] [CrossRef]
- González-Reza, R.M.; Hernández-Sánchez, H.; Quintanar-Guerrero, D.; Alamilla-Beltrán, L.; Cruz-Narváez, Y.; Zambrano-Zaragoza, M.L. Synthesis, Controlled Release, and Stability on Storage of Chitosan–Thyme Essential Oil Nanocapsules for Food Applications. Gels 2021, 7, 212. [Google Scholar] [CrossRef] [PubMed]
- Muñoz, Z.; Moret, A.; Garcés, S. Assessment of chitosan for inhibition of Colletotrichum sp. on tomatoes and grapes. Crop. Prot. 2009, 28, 36–40. [Google Scholar] [CrossRef]
- Ashrafi, M.; Bayat, M.; Mortazavi, P.; Hashemi, S.J.; Meimandipour, A. Antimicrobial effect of chitosan–silver–copper nanocomposite on Candida albicans. J. Nanostructure Chem. 2020, 10, 87–95. [Google Scholar] [CrossRef] [Green Version]
- Polinarski, M.A.; Beal, A.L.B.; Silva, F.E.B.; Bernardi-Wenzel, J.; Burin, G.R.M.; de Muniz, G.I.B.; Alves, H.J. New Perspectives of Using Chitosan, Silver, and Chitosan–Silver Nanoparticles against Multidrug-Resistant Bacteria. Part. Part. Syst. Charact. 2021, 38, 2100009. [Google Scholar] [CrossRef]
- Kim, Y.S.; Song, M.Y.; Park, J.D.; Song, K.S.; Ryu, H.R.; Chung, Y.H.; Chang, H.K.; Lee, J.H.; Oh, K.H.; Kelman, B.J.; et al. Subchronic oral toxicity of silver nanoparticles. Part. Fibre Toxicol. 2010, 7, 20. [Google Scholar] [CrossRef] [PubMed] [Green Version]
- Kozicki, M.; Kołodziejczyk, M.; Szynkowska, M.; Pawlaczyk, A.; Leśniewska, E.; Matusiak, A.; Adamus, A.; Karolczak, A. Hydrogels made from chitosan and silver nitrate. Carbohydr. Polym. 2016, 140, 74–87. [Google Scholar] [CrossRef] [PubMed]
- Zhang, Z.; He, T.; Yuan, M.; Shen, R.; Deng, L.; Yi, L.; Sun, Z.; Zhang, Y. The in situ synthesis of Ag/amino acid biopolymer hydrogels as mouldable wound dressings. Chem. Commun. 2015, 51, 15862–15865. [Google Scholar] [CrossRef]
- Kim, J.S.; Kuk, E.; Yu, K.N.; Kim, J.-H.; Park, S.J.; Lee, H.J.; Kim, S.H.; Park, Y.K.; Park, Y.H.; Hwang, C.-Y.; et al. Antimicrobial effects of silver nanoparticles. Nanomed. Nanotechnol. 2007, 3, 95–101. [Google Scholar] [CrossRef]
- Sun, Z.; Lv, F.; Cao, L.; Liu, L.; Zhang, Y.; Lu, Z. Multistimuli-Responsive, Moldable Supramolecular Hydrogels Cross-Linked by Ultrafast Complexation of Metal Ions and Biopolymers. Angew. Chem. Int. Ed. 2015, 54, 7944–7948. [Google Scholar] [CrossRef]
- Hernández, R.B.; Franco, A.P.; Yola, O.R.; López-Delgado, A.; Felcman, J.; Recio, M.A.L.; Mercê, A.L.R. Coordination study of chitosan and Fe3+. J. Mol. Struct. 2008, 877, 89–99. [Google Scholar] [CrossRef]
- Qu, J.; Hu, Q.; Shen, K.; Zhang, K.; Li, Y.; Li, H.; Zhang, Q.; Wang, J.; Quan, W. The preparation and characterization of chitosan rods modified with Fe3+ by a chelation mechanism. Carbohydr. Res. 2011, 346, 822–827. [Google Scholar] [CrossRef] [PubMed]
- Biao, L.; Tan, S.; Wang, Y.; Guo, X.; Fu, Y.; Xu, F.; Zu, Y.; Liu, Z. Synthesis, characterization and antibacterial study on the Chitosan–functionalized Ag nanoparticles. Mat. Sci. Eng. C 2017, 76, 73–80. [Google Scholar] [CrossRef] [PubMed]
- Wakshlak, R.B.; Pedahzur, R.; Avnir, D. Antibacterial activity of silver-killed bacteria: The “zombies” effect. Sci. Rep. 2015, 5, 9555. [Google Scholar] [CrossRef] [PubMed] [Green Version]
- Nakamura, C.V.; Ishida, K.; Faccin, L.C.; Filho, B.P.D.; Cortez, D.A.G.; Rozental, S.; de Souza, W.; Ueda-Nakamura, T. In vitro activity of essential oil from Ocimum gratissimum L. against four Candida species. Res. Microbiol. 2004, 155, 579–586. [Google Scholar] [CrossRef] [PubMed]
- Boxi, S.S.; Mukherjee, K.; Paria, S. Ag doped hollow TiO2 nanoparticles as an effective green fungicide against Fusarium solani and Venturia inaequalis phytopathogens. Nanotechnology 2016, 27, 085103. [Google Scholar] [CrossRef]
- Tian, J.; Ban, X.; Zeng, H.; Huang, B.; He, J.; Wang, Y. In vitro and in vivo activity of essential oil from dill (Anethum graveolens L.) against fungal spoilage of cherry tomatoes. Food Control 2011, 22, 1992–1999. [Google Scholar] [CrossRef]
- Siva, K.K.; Evgen, P.; Monserrat, H.I.; Josué, D.M.; Milton, V.L.; Yuri, K.; Isaac, C.S.; Gabriel, L.B. Chitosan/silver nanocomposites: Synergistic antibacterial action of silver nanoparticles and silver ions. Eur. Polym. J. 2015, 67, 242–251. [Google Scholar]
- Mei, L.; Xu, Z.; Shi, Y.; Lin, C.; Jiao, S.; Zhang, L.; Li, P. Multivalent and synergistic chitosan oligosaccharide-Ag nanocomposites for therapy of bacterial infection. Sci. Rep. 2020, 10, 10011. [Google Scholar] [CrossRef]
- Huang, L.; Dai, T.; Xuan, Y.; Tegos, G.P.; Hamblin, M.R. Synergistic combination of chitosan acetate with nanoparticle silver as a topical antimicrobial: Efficacy against bacterial burn infections. Antimicrob. Agents. Chemother. 2011, 55, 3432–3438. [Google Scholar] [CrossRef] [Green Version]
- WHO (World Health Organization). Silver in Drinking-Water; [WHO/HEP/ECH/WSH/2021.7]; World Health Organization: Geneva, Switzerland, 2021.
- WHO (World Health Organization). Recommendations. In Guidelines for Drinking-Water Quality, 2nd ed.; World Health Organization: Geneva, Switzerland, 1993; Volume 1. [Google Scholar]
- Chen, Y.; Guo, Q.; Wei, J.; Zhang, J.; Zhang, Z.; Wang, J.; Wu, B. Inhibitory effect and mechanism of nitric oxide (NO) fumigation on fungal disease in Xinjiang Saimaiti dried apricots. LWT-Food Sci. Technol. 2019, 116, 108507. [Google Scholar] [CrossRef]

Publisher’s Note: MDPI stays neutral with regard to jurisdictional claims in published maps and institutional affiliations. |
© 2022 by the authors. Licensee MDPI, Basel, Switzerland. This article is an open access article distributed under the terms and conditions of the Creative Commons Attribution (CC BY) license (https://creativecommons.org/licenses/by/4.0/).
Share and Cite
He, W.; Zhu, Y.; Chen, Y.; Shen, Q.; Hua, Z.; Wang, X.; Xue, P. Inhibitory Effect and Mechanism of Chitosan–Ag Complex Hydrogel on Fungal Disease in Grape. Molecules 2022, 27, 1688. https://doi.org/10.3390/molecules27051688
He W, Zhu Y, Chen Y, Shen Q, Hua Z, Wang X, Xue P. Inhibitory Effect and Mechanism of Chitosan–Ag Complex Hydrogel on Fungal Disease in Grape. Molecules. 2022; 27(5):1688. https://doi.org/10.3390/molecules27051688
Chicago/Turabian StyleHe, Weizhong, Yajuan Zhu, Yan Chen, Qi Shen, Zhenyu Hua, Xian Wang, and Peng Xue. 2022. "Inhibitory Effect and Mechanism of Chitosan–Ag Complex Hydrogel on Fungal Disease in Grape" Molecules 27, no. 5: 1688. https://doi.org/10.3390/molecules27051688
APA StyleHe, W., Zhu, Y., Chen, Y., Shen, Q., Hua, Z., Wang, X., & Xue, P. (2022). Inhibitory Effect and Mechanism of Chitosan–Ag Complex Hydrogel on Fungal Disease in Grape. Molecules, 27(5), 1688. https://doi.org/10.3390/molecules27051688

